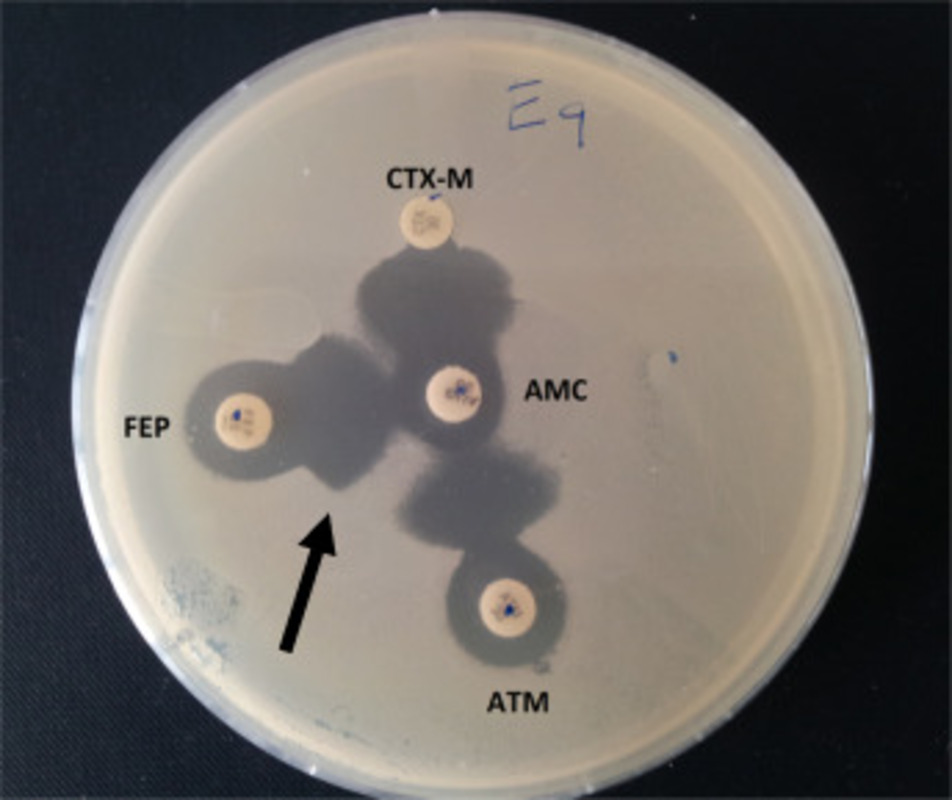
Методы обнаружения ESBL

Недавний отчет Центра по контролю и профилактике заболеваний США (CDC) показал, что после возникновения пандемии COVID-19 резистентность к антибиотикам возросла не менее чем на 15%.
В частности, среди энтеробактерий, продуцирующих бета-лактамазы расширенного спектра (ESBL), этот показатель вырос до 32%. К этой группе относятся E. coli, K. pneumoniae, K. oxytoca и P. mirabilis.
ESBL - это β-лактамазы, способные придавать резистентность к β-лактамным антибиотикам, таким как пенициллины, цефалоспорины первого, второго и третьего поколений, азтреонам (но не цефамицины или карбапенемы). Ключевой особенностью этих ферментов является то, что они гидролизируют антибиотики, но ингибируются ингибиторами β-лактамаз, такими как клавулановая кислота, тазобактам и сульбактам. Таким образом, диагностические анализы используют эту ключевую характеристику для разработки методов скрининга продуцентов ESBL, о которых речь пойдет ниже.

Иллюстрация 1. Диско-диффузионный тест для выявления ESBL. (A) Разница >5 мм между дисками цефотаксима (CTX) и цефотаксима/клавулановой кислоты (CTX/CLA), а также дисками цефтазидима (CAZ) и цефтазидима/клавулановой кислоты (CAZ/CLA) свидетельствует о наличии ESBL-продуцента. (B) Разница <5 мм между дисками CTX и CTX/CLA, а также CAZ и CAZ/CLA не свидетельствует о наличии ESBL-продуцента.
Гены, кодирующие ESBL, находятся на плазмидах, которые обеспечивают быстрый и легкий перенос между энтеробактериями, а также некоторыми неэнтеробактериями. TEM-1, одна из первых плазмид, кодирующих β-лактамазные ферменты, была идентифицирована в E. coli. Другой фермент, SHV1, был впоследствии обнаружен в Klebsiella. Эти первоначальные β-лактамазы были узкого спектра действия, но мутации привели к появлению ферментов с широким спектром активности, гидролизирующих многие широко используемые антибиотики. Сегодня существует более 100 вариантов этих ферментов, которые способствуют распространению резистентности по всему миру. Наиболее распространенной ESBL на сегодняшний день является CTX-M - фермент, происходящий от вида Kluyvera. Резистентность к CTX-M, кодируемая CTX-M, в настоящее время зарегистрирована среди представителей семейства Enterobacterales, а также P. aeruginosa и Acinetobacter sp. Другие семейства ESBL включают IRT, CMT, GES, PER, VEB, BEL, TLA, SFO и OXY.
Выявление продуцентов ESBL
Наиболее распространенным методом скрининга ESBL является диско-диффузионный тест с клавулановой кислотой и цефотаксимом и/или цефтазидимом, также называемый синергетическим тестом с двумя дисками (илл. 1). Продуценты ESBL резистентны к цефотаксиму и цефтазидиму. Однако присутствие клавулановой кислоты восстанавливает активность цефотаксима и цефтазидима, делая организм чувствительным. Если активность одного из этих цефалоспоринов III поколения восстанавливается под действием клавулановой кислоты, то наличие ESBL подтверждается.
Положительная интерпретация ESBL происходит при увеличении диаметра зоны на ≥5 мм для любого из тестируемых агентов в комбинации с клавуланатом по сравнению с диаметром зоны для одного из агентов. Возможен также подход с использованием микроразведений в бульоне. Положительной интерпретацией ESBL будет снижение МИК любого из тестируемых агентов в комбинации с клавуланатом на ≥3 "2-кратных" концентраций по сравнению с МИК одного из тестируемых агентов.
Рекомендации Института клинических лабораторных исследований и стандартов (CLSI) не требует проведения ESBL-тестирования для Enterobacterales, но тестирование рекомендуется для профилактики инфекций или в рамках конкретной практики в учреждениях. Если для одного или нескольких цефалоспоринов используются текущие брейкпоинты, то рекомендуется предоставлять информацию о МИК в обычном режиме. Однако если используются устаревшие брейкпоинты для цефалоспоринов, то все пенициллины, цефалоспорины и азтреонам следует указывать как резистентные. Следует отметить, что между рекомендациями CLSI и Европейского комитета по тестированию на чувствительность к противомикробным препаратам (EUCAST) могут быть незначительные различия, и каждое конкретное учреждение должно само решать, каким рекомендациям следовать.
К другим фенотипическим методам выявления ESBL относятся имеющиеся в продаже тест-системы, в которых встроен фенотипический скрининг ESBL. Эффективность зависит от производителя и составляет 84-99% и 52-78% для чувствительности и специфичности, соответственно. К другим коммерческим методам относятся колориметрические тесты, такие как Rapid ESBL Screen Kit (Rosco Diagnostica), который выявляет продуцентов ESBL без дифференциации между различными ферментами. Этот тест имеет чувствительность >90% при исследовании культивированных изолятов или различных образцов (кровь, моча или дыхательные пути), но специфичность варьирует. Существует также экспресс-тест (NG-Test CTX-M MULTI assay, NG Biotech, Guipry, France), разработанный для выявления ферментов CTX-M, чувствительность и специфичность которого составляет >98%.
Развитие молекулярного тестирования позволило включить гены ESBL в качестве мишеней в коммерчески доступные диагностические панели. Поскольку CTX-M является наиболее распространенным геном ESBL, коммерческие платформы, одобренные FDA, включая панели для идентификации культур крови и пневмонии, включают маркер CTX-M в качестве мишени. Чувствительность варьирует в пределах 85-95% при различной специфичности. Недавно панель генов AMR компании Acuitas стала первым диагностическим тестом, одобренным FDA, включающим широкую панель из 28 маркеров AMR, в том числе гены семейства ESBL, такие как TEM и SHV, с положительным прогнозом 98,5% и 100%, соответственно.
В целом существуют различные методы выявления продуцентов ESBL, и их обнаружение может оказаться непростым делом, поскольку существует множество семейств генов ESBL и в целом механизмы антибиотикорезистентности у грамотрицательных организмов гетерогенны. Тем не менее, учитывая рост резистентности к антимикробным препаратам, выявление продуцентов ESBL является жизненно важным как для лечения пациентов, так и для наблюдения за ними.